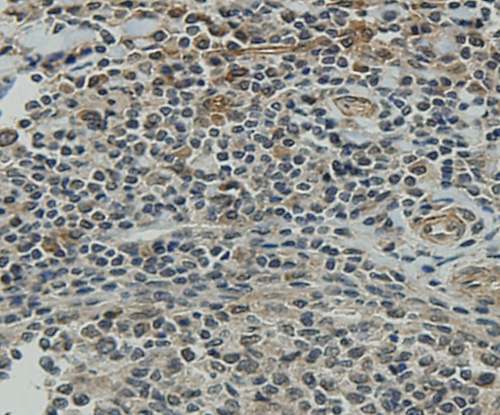

-
Product Name
Anti-CCDC51 antibody
- Documents
-
Description
Mouse monoclonal antibody to CCDC51
-
Tested applications
WB, IHC-P
-
Species reactivity
Human
-
Alternative names
MITOK antibody
-
Isotype
Mouse IgG1
-
Preparation
This antigen of this antibody was recombinant protein
-
Clonality
Monoclonal
-
Formulation
Liquid, 1*PBS (pH7.4), 0.2% BSA, 40% Glycerol. Preservative: 0.05% Sodium Azide.
-
Storage instructions
Store at +4℃ after thawing. Aliquot store at -20℃ or -80℃. Avoid repeated freeze / thaw cycles.
-
Applications
WB: 1:500-1:1,000
IHC-P: 1:50-1:200
-
Validations

Fig1: Western blot analysis of CCDC51 on recombinant protein using anti-CCDC51 antibody at 1/1,000 dilution.
Fig2: Immunohistochemical analysis of paraffin-embedded human tonsil tissue using anti-CCDC51 antibody. Counter stained with hematoxylin

Fig3: Immunohistochemical analysis of paraffin-embedded human lung tissue using anti-CCDC51 antibody. Counter stained with hematoxylin.

Fig4: Immunohistochemical analysis of paraffin-embedded human liver tissue using anti-CCDC51 antibody. Counter stained with hematoxylin.

Fig5: Immunohistochemical analysis of paraffin-embedded human tonsil tissue using anti-CCDC51 antibody. Counter stained with hematoxylin.

Fig6: Immunohistochemical analysis of paraffin-embedded human thyroid tissue using anti-CCDC51 antibody. Counter stained with hematoxylin.

Fig7: Immunohistochemical analysis of paraffin-embedded human spleen tissue using anti-CCDC51 antibody. Counter stained with hematoxylin.

Fig8: Immunohistochemical analysis of paraffin-embedded human breast tissue using anti-CCDC51 antibody. Counter stained with hematoxylin.

Fig9: Immunohistochemical analysis of paraffin-embedded human pancreas tissue using anti-CCDC51 antibody. Counter stained with hematoxylin.
- Background
-
References
- Jerber J et al. The coiled-coil domain containing protein CCDC151 is required for the function of IFT-dependent motile cilia in animals. Hum Mol Genet 23(3):563-77 (2014).
Related Products / Services
Please note: All products are "FOR RESEARCH USE ONLY AND ARE NOT INTENDED FOR DIAGNOSTIC OR THERAPEUTIC USE"
